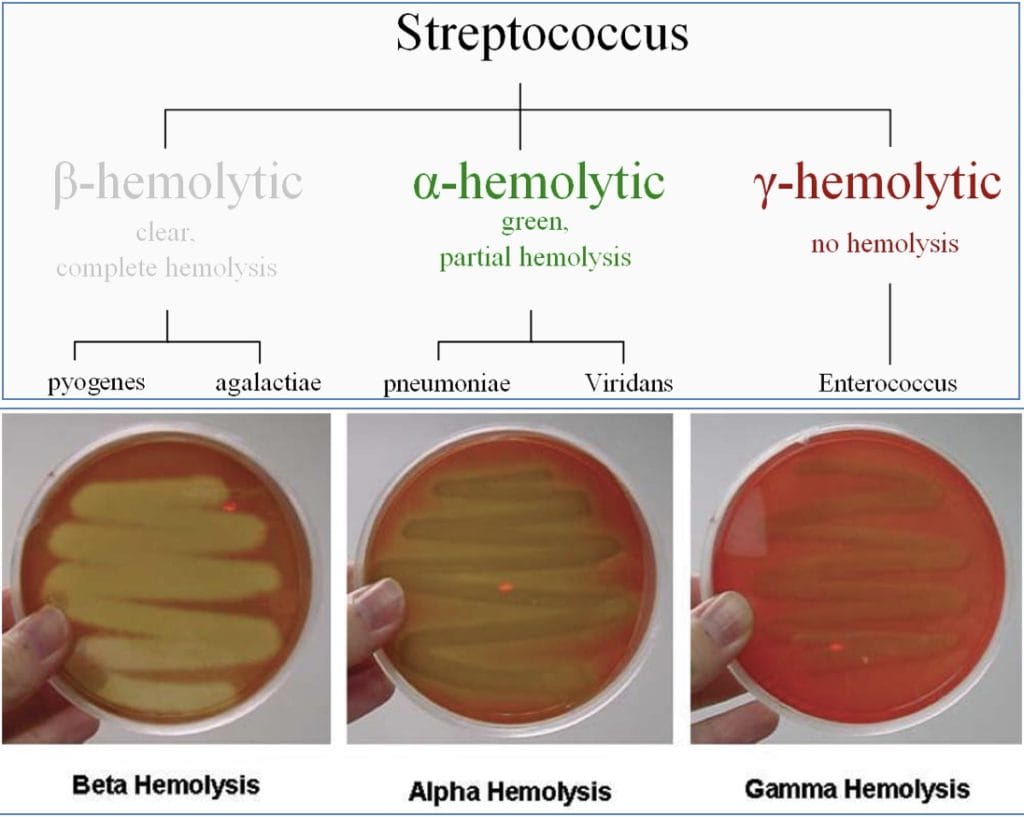
Streptococcus Bacteria

Table of Contents
Overview – Microbiology of Bacteria
The microbiology of bacteria is fundamental to clinical medicine, as bacteria are responsible for a wide range of infectious diseases. Understanding their structural features, classification systems, virulence factors, and resistance mechanisms helps final-year medical students interpret pathology results, guide antibiotic choice, and manage bacterial infections effectively. This page covers the key morphological, immunological, and clinical properties of bacteria, including Gram staining, bacterial toxins, immune evasion, and resistance.
Bacterial Cell Structure
- Prokaryotic, single-celled organisms
- DNA-based genome (circular chromosome), no distinct nucleus
- Three-layer structure:
- Plasma membrane
- Cell wall
- Gram-positive: Thick peptidoglycan + teichoic acid
- Gram-negative: Thin peptidoglycan + outer lipid membrane (with lipopolysaccharide [LPS])
- Capsule: Polysaccharide layer – resists phagocytosis, detergents, dehydration
- Pili/Fimbriae – Adhesion to host/bacteria
- Flagella – Mobility


Taxonomy & Classification
- Binomial nomenclature: Genus species (e.g. Staphylococcus aureus)


Staining
- Gram stain:
- Gram-positive: Blue/purple; thick peptidoglycan
- Gram-negative: Pink/red; lipid-rich outer membrane (LPS = endotoxin)


- Acid-fast stain (e.g. Mycobacterium tuberculosis):
- Ziehl–Neelsen stain → acid-fast bacilli = bright red


- Respiration: Aerobic vs anaerobic
- Cell shape: Cocci, bacilli, spiral


- Grouping: Single / Diplo- / Strepto- / Staphylo-


Bacterial Virulence Factors
- Aid in colonisation, immune evasion, nutrient acquisition
- Endotoxins (Gram-negative):
- Lipopolysaccharide (LPS) → triggers TLRs → cytokine release → septic shock
- Exotoxins (Gram-positive):
- e.g. Staphylococcus superantigen, tetanus toxin


- Immune evasion:
- Antigenic variation
- Capsule to resist phagocytosis
- Intracellular survival mechanisms (e.g. preventing phagosome-lysosome fusion)
- Superoxide dismutase to neutralise oxidative burst
- Superantigens → inappropriate T-cell activation


Pathological Consequences
Exotoxins (Gram-positive)
- Secreted toxins → illness without invasion
- e.g. Tetanus, botulism
- Toxic Shock Syndrome:
- Superantigen → massive cytokine release → fever, hypotension, MOF (multi-organ failure)
Endotoxins (Gram-negative)
- LPS released upon bacterial lysis
- Septic Shock:
- LPS binds to TLR4 → cytokines (IL-1, TNF-α) → hypotension, vasodilation, MOF
- Important: Avoid bactericidal antibiotics during septic shock to prevent exacerbating LPS release
Septic vs Toxic Shock
- Septic Shock:
- Gram-negative
- LPS-mediated (released on lysis)
- Avoid bactericidals in early treatment
- Toxic Shock:
- Gram-positive
- Superantigen-mediated
- Treat with bactericidals (no endotoxin concern)
Antibiotic Susceptibility
Selective Toxicity
- Exploits structural differences between bacteria & host cells
Key Steps in Antibiotic Action
- Active form
- Reaches site
- Binds bacterial surface (X)
- Enters cell (X)
- Binds intracellular target (X)
- Kills/inhibits growth (X)
(X = potential resistance points)
Types of Antibiotics
- Bactericidal – kills bacteria
- Bacteriostatic – inhibits growth
- By Target Site:
- Cell wall: β-lactams, glycopeptides
- Protein synthesis: aminoglycosides, macrolides
- Nucleic acid synthesis: quinolones, sulphonamides
- Cell membrane: colistin, polymyxins
- By Chemical Structure:
- β-lactams, macrolides, tetracyclines, glycopeptides, aminoglycosides, quinolones, sulphonamides, etc.
Antibiotic Resistance
Definitions
- Resistance = organism not inhibited/killed by normal drug dose
- Mutation rates are high due to rapid bacterial replication
Mechanisms
- Intrinsic resistance: predictable within species (e.g. Gram-negatives vs vancomycin)
- Acquired resistance: mutations, plasmids, or both
- May affect: entry, drug target, enzyme breakdown


Categories
- Susceptible – Patient is likely to respond to treatment with that antibiotic at normal doses
- Intermediate – Higher doses are needed to ensure treatment success
- Resistant – Patient NOT likely to respond to treatment with that antibiotic at normal doses
Clinically Important Resistant Organisms
- MRSA – altered penicillin-binding protein, β-lactamase
- VRE – altered vancomycin target site (Van A/B)
- VISA – thickened cell wall traps vancomycin
- ESBL – β-lactamase hydrolyses β-lactams
- MDR-GNote – multi-drug resistant Gram-negative bacilli
Common Pathogenic Bacteria
Gram-positive Bacteraemia
- Staphylococcus aureus: coagulase positive, highly virulent
- Staphylococcus epidermidis: coagulase negative
- Streptococcus pneumoniae: α-haemolytic, common cause of pneumonia
- Viridans streptococci: dental flora, endocarditis risk
- Group A Streptococcus: β-haemolytic – rheumatic fever, glomerulonephritis
- Enterococcus: normal gut flora, antibiotic resistant

Gram-negative Bacteraemia
- Neisseria meningitidis: bacterial meningitis
- Neisseria gonorrhoeae: gonorrhoea
- Escherichia coli: food poisoning, UTI
- Klebsiella pneumoniae: pneumonia, often in immunocompromised hosts
Summary – Microbiology of Bacteria
The microbiology of bacteria encompasses their structure, classification, virulence factors, resistance mechanisms, and clinical significance. Differentiating between Gram-positive and Gram-negative organisms, recognising virulence traits such as endotoxins or capsules, and understanding antibiotic resistance patterns are essential skills for managing infectious disease. For more foundational information, see our Microbiology & Public Health Overview page.